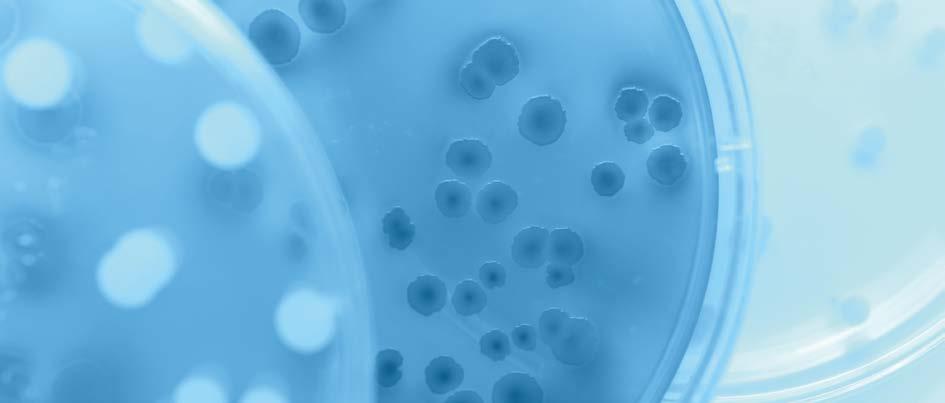

TĒNĀ KOUTOU,
On behalf of the Academy and Royal Society Te Apārangi, I congratulate the new Fellows. These distinguished academics have made exceptional contributions to knowledge in their fields and across disciplinary boundaries. The election process is rigorous and these new Fellows, the 2023 cohort, can be rightfully proud that their outstanding achievements have been recognised by their peers in this way. Their election adds to the depth of knowledge held within the Academy. We look forward to their participation and help in supporting the purpose of the Society to engage with New Zealanders on topics important to all and to recognise outstanding researchers working in Aotearoa.
Ka rawe!
DISTINGUISHED PROFESSOR GEOFF CHASE FRSNZ
ACADEMY EXECUTIVE COMMITTEE CHAIR
NGĀ AHUREI HOU A TE APĀRANGI NEW FELLOWS 2023 3

MĀ TE KIMI KA KITE, MĀ TE KITE KA MŌHIO, MĀ TE MŌHIO KA MĀRAMA.
SEEK AND DISCOVER, DISCOVER AND KNOW, KNOW AND BECOME ENLIGHTENED.
Twenty-one Ngā Ahurei hou a Te Apārangi new Fellows and one He Ahurei Honore a Te Apārangi Honorary Fellow were elected to the Academy of the Royal Society Te Apārangi in the 2023 cohort for their distinction as world leaders in their areas of research and scholarship.
MISSION OF THE ACADEMY
The mission of the Academy is to honour, recognise, and encourage outstanding achievement in the sciences, technologies, and humanities, as well as to assist and support the activities of Royal Society Te Apārangi.
ITS OBJECTIVES ARE TO:
• recognise outstanding achievements in the sciences, technologies, and humanities
• encourage and stimulate high standards of endeavour and achievement in these fields
• reward excellence in the broad areas of science, technology, and humanities covered by the Academy
• provide independent and non partisan advice to the Royal Society Te Apārangi Council, government policy-makers, and the wider community on science, technology, and the humanities.
5 NGĀ AHUREI HOU A TE APĀRANGI NEW FELLOWS 2023
HOW TO GET INVOLVED
We rely on our Fellows and their diverse expertise to assist us in our activities to achieve our goals. Whether signalling a commitment to promoting your area of research or contributing through mentoring, we would like to hear from you. We are particularly interested in ideas aligned to the Society’s long-term strategy. Submissions for one-off or particular activities can be made to the Academy Executive Officer, Marc Rands marc.rands@royalsociety.org.nz who will outline the process under which proposals are considered.
READ MORE: ROYALSOCIETY.ORG.NZ/WHO-WE-ARE/OUR-STRATEGY
6 NGĀ AHUREI HOU A TE APĀRANGI NEW FELLOWS 2023

PROFESSOR FRANK BLOOMFIELD FRSNZ
WAIPAPA TAUMATA RAU THE UNIVERSITY OF AUCKLAND
Frank Bloomfield is a neonatologist recognised internationally for his work in neonatal nutrition, the long-term consequences of altered foetal growth and nutrition, and leadership in neonatology perinatology for high-risk pregnancies. His work has led to global changes in practice with respect to parenteral (bypassing gastrointestinal system) nutrition solutions for extremely preterm babies. He has informed international guidelines on normal ammonia concentrations in these babies and significantly advanced understanding of refeeding syndrome in preterm babies. Nationally, he led work identifying ethnic disparity in survival from critical congenital heart disease and the subsequent development, and implementation, of national guidelines for screening for neonatal hypoxaemia (low blood oxygen) and the development of a roadmap for a national clinical trials infrastructure that is the blueprint for Te Whatu Ora and Manatū Hauora.


PROFESSOR JUDY BROWN FRSNZ
TE HERENGA WAKA—VICTORIA UNIVERSITY OF WELLINGTON
Judy Brown initiated research into dialogic accounting, pluralism, and democracy. She is internationally recognised as a leader in critical accounting, and social and environmental accounting. Her work challenges the emphasis in conventional accounting on finance capital and seeks to develop pluralistic accounting and accountability theory and practices. Judy’s research leadership stems from combining deep disciplinary knowledge with innovative synthesis of ideas and concepts from other disciplines, in particular democratic theory. Her sole-authored paper on ‘taking pluralism seriously’ is regarded as a seminal paper, while her other works have deepened understanding of how accounting and politics are entwined. There has been significant academic uptake and policy-related impacts of her work.

NGĀ AHUREI HOU A TE APĀRANGI NEW FELLOWS 2023 7
DR KEVIN DAVIES FRSNZ

RANGAHAU AHUMĀRA KAI PLANT & FOOD RESEARCH
Kevin Davies has made a distinguished contribution to advancing understanding of plant pigmentation and the stress-tolerance mechanisms of plants, including the discovery of a new class of plant pigments. Based at Plant & Food Research, Kevin is the international authority on how plants control the production of specialised metabolites to provide colour to flowers and fruit and to withstand environmental challenges such as UV-B light. His work has explained the induction of red colour in leaves to protect against environmental stress and how flowers produce complex colour patterning to attract pollinators. The impact of the knowledge he has generated ranges from aiding selection of new horticultural varieties, to theorising how specialised metabolites may have helped plants to first emerge on land around five hundred million years ago.


AGRESEARCH
Kenneth Dodds is a leader in statistics and bioinformatics. Globally, he is known for developing and implementing statistical tools for genetics and breeding, especially in livestock. He led the mapping of genes for major international projects on livestock species when genetic maps had only been achieved in humans or inbred populations. Kenneth has been a global leader in combining new statistical tools with genetic analysis. These tools are used in breeding programmes for diverse species across the globe, as well in conservation of endangered species. His leadership of methodology and software allowed genomic regions in livestock to be associated with diverse production traits. Recently, he led the development of statistical tools for the application of low-cost DNA sequencing for genetic improvement.

NGĀ AHUREI HOU A TE APĀRANGI NEW FELLOWS 2023 8

PROFESSOR NICOLA GASTON FRSNZ
WAIPAPA TAUMATA RAU THE UNIVERSITY OF AUCKLAND
Nicola Gaston is an eminent theoretical physicist who studies materials through advanced computational simulations. Her calculations solve the equations that describe the quantum mechanical structure of the atoms in unconventional materials, and predict the properties that depend upon the detailed arrangement of those atoms in space.
Nicola’s research is internationally recognised for providing particularly important insights into the behaviour of low-temperature liquid metals. Her findings have enabled others to use these materials in a range of important technological applications. She also co-directs the MacDiarmid Institute for Advanced Materials and Nanotechnology in New Zealand, leading it to achieve its vision of fostering and supporting world-class materials research that addresses the key sustainability challenges of our times.


TE WHARE WĀNANGA O OTĀGO UNIVERSITY OF OTAGO
Michelle Glass is an internationally leading pharmacologist, whose research has provided new understanding of the role of cannabinoid receptors in human brains. Her work has improved understanding of new drugs and compounds targeted to cannabinoid receptors and to understanding the harm caused by synthetic cannabinoids. Michelle has played a key role in educating the public on the potential harm of recreational use of synthetic cannabinoids. As a role model and mentor for a generation of young scientists, Michelle has not only undertaken revolutionary basic biomedical research, but has also informed and influenced drug policy and education in New Zealand and internationally. She has been a critical contributor to the recent debate on medicinal and recreational cannabis.

NGĀ AHUREI HOU A TE APĀRANGI NEW FELLOWS 2023 9

PROFESSOR NICHOLAS GOLLEDGE FRSNZ
TE HERENGA WAKA—VICTORIA UNIVERSITY OF WELLINGTON
Nicholas Golledge, a climate scientist, led the establishment and subsequent development of Antarctic ice-sheet modelling capability in New Zealand, becoming a global leader in this field. By bringing together observational and theoretical approaches, he has made profound advances in understanding how the Antarctic Ice Sheet will respond to a warming climate, and the impacts that ice-sheet melting will have on global sea-level change, ocean circulation, and climate variability. Two of his fundamental discoveries are that ice-sheet melting could produce a positive feedback loop that accelerates its own retreat and discovering the 2 °C temperature-rise threshold for long-term Antarctic ice-sheet stability. Through a series of high-impact publications, his research has led to significant media coverage, international recognition, and policy impact. He was a Lead Author for the 2021 Intergovernmental Panel on Climate Change Sixth Assessment Report, and leads the Future Projections Expert Group of the MBIE-funded Antarctic Science Platform.

PROFESSOR DAVID GRATTAN

TE WHARE WĀNANGA O OTĀGO UNIVERSITY OF OTAGO
David Grattan is a world leader in the field of neuroendocrinology and is considered the foremost expert investigating the actions on the central nervous system of the anterior pituitary hormone prolactin – a hormone primarily responsible for lactation and breast development. Studies from his laboratory have led the way for understanding prolactin’s actions in the central nervous system. In the past 10 years, he has characterised several prolactin-sensitive neuronal networks in the brain, and developed multiple transgenic tools to probe their function. He has pioneered a new understanding of prolactin’s important role in coordinating the adaptations in the maternal brain during pregnancy, and the role of prolactin in promoting parental behaviour in both males and females, contributing multiple high-impact publications. He is regularly invited to deliver keynote addresses and was Editor-in-Chief of the Journal of Neuroendocrinology (2009-2014), the leading specialist international journal in the field.

NGĀ AHUREI HOU A TE APĀRANGI NEW FELLOWS 2023 10
PROFESSOR JUSTIN HODGKISS


TE HERENGA WAKA—VICTORIA UNIVERSITY OF WELLINGTON
Justin Hodgkiss has developed ultra-fast optical tools that reveal how different materials, from skin to solar cells, respond to light. Justin and his team discovered how the brown pigment, eumelanin, offers protection from UV light, resolving an elusive problem in photobiology, and suggesting approaches for biology-inspired sunscreens. In the case of solar photovoltaic cells, Justin’s work has resolved the key light-to-current conversion processes on the femtosecond (one millionth of a billionth of a second) timescale. In understanding the light response of candidate photovoltaic materials, Justin’s team has discovered design rules for more effective solar photovoltaic materials. These design rules are embodied in a new class of organic solar cell materials, which now display record efficiencies and are nearing commercial viability. Justin and his team have now commercialised an ultrafast spectrometer they invented, selling instruments worldwide. Justin is also Co-director of the MacDiarmid Institute that seeks to support sustainability through such discoveries.

WAIPAPA TAUMATA RAU THE UNIVERSITY OF AUCKLAND
Anthony Hōete’s (Ngāti Awa, Ngāti Rānana) innovative design has advanced New Zealand and Māori architecture worldwide. His transdisciplinary research into the built environment is holistic and unique. It embraces a broad range of disciplines, including architecture, archaeology, structural engineering, property, planning, and climate change. It enables pioneering research in the seismic resilience of traditional Māori architectural and building technologies. His architecture comes from the te ao Māori view that doesn’t distinguish the man-made from the natural world, providing a holistic view of the built environment, not one siloed into separate disciplines. He negotiated the return of Hinemihi – a marae that was taken to England in 1892. Through his WHAT_architecture practice in London, he has produced over 250 design projects, including buildings and publications. Registered as an architect in four countries, Anthony’s transnational professional practice knowledge is unrivalled. He has taught at two of the world’s top three architecture schools.

NGĀ AHUREI HOU A TE APĀRANGI NEW FELLOWS 2023 11

PROFESSOR ROD JACKSON FRSNZ
WAIPAPA TAUMATA RAU THE UNIVERSITY OF AUCKLAND
Rod Jackson is a global leader in advancing the field of epidemiology. He played a key role in identifying a New Zealand epidemic of asthma deaths in the 1980s and, with colleagues, identified its cause. Rod led development of the world’s first national guidelines to recommend that treatment decisions should be based on multifactorial prediction of the risk of cardiovascular disease (CVD) rather than single risk factors – this approach has influenced how clinicians in Aotearoa New Zealand and around the world prescribe blood-pressure-lowering and lipidlowering medications. Rod has developed unique and accessible graphical approaches for evaluation of epidemiological studies which have been translated into multiple languages. Currently, he is leading very large prospective studies involving over 500,000 New Zealanders, for deriving and evaluating CVD riskprediction equations.


PROFESSOR LYNDA JOHNSTON FRSNZ
TE WHARE WANANGA O WAIKATO UNIVERSITY OF WAIKATO
Lynda Johnston’s innovative and challenging scholarship on space, place, and sexuality has transformed the way that human geographers and those in related disciplines understand people’s relationship with place. She has shown an unwavering commitment to creating a fairer, more inclusive world, drawing attention to the ways in which sexism, homophobia, and transphobia shape communities. Because of Lynda’s work, sex and sexuality are no longer missing from geographical theory. Through her books and articles, published in leading international journals, Lynda has established a new field often referred to as ‘queer geography.’ Here in Aotearoa, she is revered for playing a pivotal role championing the rights of the LGBTQ community through organisations such as the Rainbow Alliance Group and Hamilton Pride Incorporated. Around the world, Lynda’s work has had far-reaching impact, including advising International AIDS conferences on how to effectively collaborate with communities in HIV prevention, treatment, and support programmes.

NGĀ AHUREI HOU A TE APĀRANGI NEW FELLOWS 2023 12


DR CARWYN JONES FRSNZ
TE WĀNANGA O RAUKAWA
Carwyn Jones’s (Ngāti Kahungunu ki Te Wairoa)
Indigenous legal and constitutional research has been groundbreaking in the way it places tikanga Māori as the first law of Aotearoa New Zealand. His research has contributed to transformative change in Aotearoa, impacting the way that legal arguments are made, heard, taught, and used to guide and create legislation and public policy. Carwyn’s research draws confidently on te ao Māori, and conveys his research findings in ways that government, the courts, the Waitangi Tribunal, the wider legal profession, Iwi, hapū, and others are listening to. His research is having a significant impact in inspiring new generations of scholars to follow his approach.

PROFESSOR JOANNA KIDMAN FRSNZ
TE HERENGA WAKA—VICTORIA UNIVERSITY OF WELLINGTON
Joanna Kidman (Ngāti Maniapoto, Ngāti Raukawa) is a Professor of Māori education, and one of the few Indigenous sociologists worldwide. Her research centres on indigeneity and its role in economic, political, and cultural development, both locally and internationally. She is especially interested in the interplay of power relations between diverse groups of people. Within Aotearoa New Zealand, her research has addressed Māori and Pacific youth who have been marginalised or excluded from education and other economic and political structures, exploring how young people establish a sense of belonging and place within society, and how Māori communities have incorporated their experiences into their shared identities and histories. Her work spans higher education, comparative education, and studies of colonisation and decolonisation.

NGĀ AHUREI HOU A TE APĀRANGI NEW FELLOWS 2023 13

TE HERENGA WAKA—VICTORIA UNIVERSITY OF WELLINGTON
Martin Manning is a world-leading physical scientist, who has made influential contributions to fundamental research and communication of climate science. In the 1970s he led the first team in New Zealand reporting on greenhouse gas emissions to make advances in atmospheric gas measurements. In the 1980s, he used that research to set current international standards. He was third of eight editors for the 2007 Intergovernmental Panel on Climate Change report – Part 1: The Physical Science Basis His new approach in this report for conveying uncertainties in science to policymakers remains widely applied today. Martin co-authored the 2010 foundation publication for subsequent climate scenarios. He continues research with colleagues to address the causes of methane emissions, rising since 2007, and threatening the success of the Paris Agreement.


PROFESSOR PETER O’CONNOR FRSNZ
WAIPAPA TAUMATA RAU THE UNIVERSITY OF AUCKLAND
Peter O’Connor is internationally recognised for his research and his utilisation of the arts for social transformation. He pioneered the field of applied theatre in New Zealand and expanded his interests to encompass arts-based research projects worldwide. In 2020, he founded the Centre for Arts and Social Transformation (CAST) at the University of Auckland, where he leads cross disciplinary teams in directing research projects on the arts and social change. O’Connor focuses on creating and investigating arts projects in a wide range of contexts, including prisons, schools, and disaster zones. He leads CAST projects that tackle social issues such as racism, the rise of populism, and mental health for children and young people. His theorising of the arts post-disaster has developed new understandings of the potential for the arts to heal communities after trauma.

NGĀ AHUREI HOU A TE APĀRANGI NEW FELLOWS 2023 14

DR VINCENT O’MALLEY FRSNZ
HISTORYWORKS
Vincent O’Malley is an acclaimed historian, recognised locally and internationally for transforming how New Zealanders think about and relate to the history of their own country. He is at the forefront of efforts to ensure more people learn about the nineteenth-century New Zealand Wars, which he argues were defining and transformative conflicts in New Zealand history, along with the history of Māori and Pākehā relations more generally. Vincent is renowned for his work on the New Zealand Wars and was one of the main public figures behind the successful campaign to ensure New Zealand history is taught in all schools. His outstanding scholarship and impressive public engagement is matched by a long history of working with and for many Māori communities across Aotearoa. Vincent co-leads a cutting edge-Marsden Fund project on how ‘difficult histories’ are remembered and forgotten.


PROFESSOR MARY SEWELL
WAIPAPA TAUMATA RAU THE UNIVERSITY OF AUCKLAND
Mary Sewell is a marine biologist who is at the forefront of research on impacts of human-caused change to ocean life. Through her research on the early life stages of marine invertebrates, she has made key discoveries about factors which affect reproduction and development, such as temperature, salinity, ocean acidification, microplastics, and disease. Mary’s research into larval biology is transdisciplinary in its scope – combining field-based experimental work with physiological, biochemical, microscopic, and molecular studies, such as DNAbarcoding. She has made major advances to lifehistory theory and understanding the impacts of microplastics on marine plankton and resulting impacts on marine systems and food chains. Her expertise is internationally recognised, and she has had significant leadership roles in international and national research committees.

NGĀ AHUREI HOU A TE APĀRANGI NEW FELLOWS 2023 15

Claudine Stirling is recognised as a world-leading expert in isotope geochemistry and oversees scientific programmes of global significance. She is a Professor of Geochemistry and Director of the Centre for Trace Element Analysis – a multimillion-dollar laboratory suite for precise isotopic and concentration analysis of trace metals. The Centre is one of only a few around the world with combined expertise in the transition-metal and heavy-metal isotope systems, facilitating new research directions. The team uses trace elements and their isotopes to investigate the dynamic interactions between oceans and the atmosphere across a wide range of timescales. Claudine has a background in multidisciplinary research and drives a programme spanning chronology in the early solar system, environmental and forensic geochemistry, and climate change, with increasing emphasis on the Southern Ocean. Her discovery of uranium isotope variations in nature has led to the inception of a brand-new research discipline.


FRSNZ
TE HERENGA WAKA—VICTORIA UNIVERSITY OF WELLINGTON
William (Jeff) Tatum is a classicist at the forefront of Roman history, the poetics of Latin literature, Greek literature in imperial Rome, and Greco-Roman reception studies, including classical reception in New Zealand poetry. He is the author or editor of six influential books and close to eighty frequently cited papers or chapters. Jeff wrote the authoritative scholarly account of Rome in the fifties BCE, the final decade of the republic: it unpacks the legal and religious technicalities defining the period and explains the material and social conditions pushing Rome’s urban poor to unprecedented and often violent political participation. His work shifted theorising about the fall of the republic from an exclusive concentration on the activities of the elite to a wider, deeper engagement with Roman society at large. Jeff is currently writing a biography of Mark Antony for the University of Oxford and a history of republican Latin literature for the University of Cambridge.

NGĀ AHUREI HOU A TE APĀRANGI NEW FELLOWS 2023 16
PROFESSOR DAN ZHAO

TE WHARE WĀNANGA O WAITAHA UNIVERSITY OF CANTERBURY
Dan Zhao has made essential contributions to combustion engineering, addressing key issues in low emission, safe, and efficient engine design. He has conducted innovative research on the prediction and control of thermoacoustic instabilities, which are a barrier to improvements in engine efficiency. He has developed several new control approaches, enabling ultra-low-emission combustion systems to maintain peak performance throughout the full range of engine operating conditions. Dan has also been developing CO2-free combustion technologies using hydrogen and ammonia fuels. His interdisciplinary research leadership has led to three hundred fully refereed publications in scientific journals, including Nature Communications Physics. As a science communicator, he has served as the chief or senior editor, for seven top-tier journals, and has founded the first New Zealand-based chartered branch of the American Institute of Aeronautics and Astronautics, remaining as its academic advisor.

NGĀ AHUREI HOU A TE APĀRANGI NEW FELLOWS 2023 17